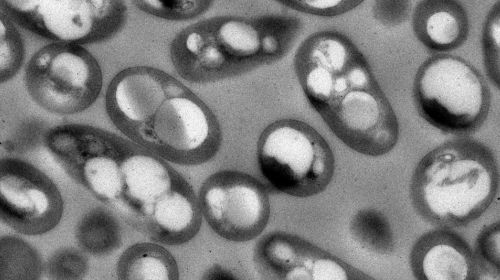

Abrir en el navegador
Abrir en el navegador
|

|

|
Entrevistas
|

|
Rosario Cerrato
Directora de Innovación en Ingulados
Tenemos que ser conscientes que la salud de personas, animales y medioambiente, esta interconectada y cualquier actuación en uno de ellos repercute...
Continuar leyendo
|
|

|
Noticias destacadas
|

|
Cannabisforum 2024 presenta su concurso de posters científicos
Farmaforum X Edición ha anuciado su convocatoria para la presentación de posters científicos en Cannabisforum 2024....
Continuar leyendo
|
|

|

|
Farmaforum 2024: María Jesús Lamas, Directora de la AEMPS, inaugurará el evento
Farmaforum, el evento de referencia en la industria farmacéutica, anuncia la participación de María Jesús...
Continuar leyendo
|
|

|
Valtria, el mejor partner para proyectos de terapias avanzadas
Asistimos a una revolución tecnológica en el campo de la medicina, lo que se traduce en mejoras para la salud, calidad y esperanza...
Continuar leyendo
|
|

|
AseBio Te cuenta
|

|
La biotecnología sienta las bases del presente y futuro de la salud e impulsa el enfoque One Health
Con motivo del Día Mundial de la Salud que se celebra este 7 de abril, la Organización Mundial de la Salud (OMS) alerta...
Continuar leyendo
|
|

|

|
Quibim presenta su herramienta automatizada de IA para el diagnóstico por RM de enfermedades hepáticas difusas
Quibim, compañía global pionera en biomarcadores de imagen para la medicina de precisión, anuncia hoy el lanzamiento...
Continuar leyendo
|
|

|
Bioga Comunica
|

|
La ciudad de Vigo acogerá este 12 y 13 de junio la próxima edición de "Galicia Biodays"
El Auditorio y Palacio de Congresos Mar de Vigo acogerá los próximos días 12 y 13 de junio "Galicia...
Continuar leyendo
|
|

|
TERAV, innovación española en Terapias Avanzadas
|

|
Miembros de TERAV participan en los primeros bioimplantes cardíacos, para tratar a pacientes con infarto de miocardio
Los resultados prometedores obtenidos en el ensayo clínico con un medicamento pionero de terapia avanzada llamado PeriCord, que busca...
Continuar leyendo
|
|

|

|
Actualidad de Farmabiotec
|

|
IbS.GRANADA y Fundación FIBAO enfatizan la importancia de ayudas financieras en 'BioMed & Tech Talks'
La tercera jornada de 'BioMed & Tech Talks: Tu cita con la investigación y la innovación' ha destacado el prominente...
Continuar leyendo
|
|

|

|
Científicos del Instituto de Neurociencias descubren la implicación de linajes paralelos de células madre en la creación de neuronas
El desarrollo de la corteza cerebral depende en gran medida de las células madre que se encargan de generar neuronas, las células...
Continuar leyendo
|
|

|
La Real Sociedad Española de Química y Lilly convocan sus premios anuales de investigación
La Real Sociedad Española de Química y Lilly convocan los XXII Premios de Investigación para Alumnos de Doctorado,...
Continuar leyendo
|
|

|

|
Reig Jofre anuncia una gran inversión para fortalecer la producción de principios activos biotecnológicos
Reig Jofre ha dado un paso significativo hacia la expansión de su cartera de productos al anunciar una inversión de 5,8...
Continuar leyendo
|
|

|
El Basque Health Cluster y BIOEF colaborarán en aspectos como I+D+i o internacionalización
El Cluster de Biociencias y Salud de Euskadi ha firmado un convenio de colaboración con la Fundación Vasca de Innovación...
Continuar leyendo
|
|

|

|
Científicos españoles desarrollan hidrogeles magnéticos para regenerar la médula espinal
Investigadores del Instituto de Ciencia de Materiales de Madrid (ICMM-CSIC) han dado un paso significativo en la búsqueda de nuevas...
Continuar leyendo
|
|

|
La Sociedad Española de Farmacogenética y Farmacogenómica apuesta por la formación de los profesionales sanitarios para impulsar la implementación de la Farmacogenética
La “Farmacogenética”, parte integral de la medicina personalizada de precisión, estudia cómo las variantes...
Continuar leyendo
|
|

|

|
La investigación biomédica es crucial para el futuro de España
En un momento crucial para el avance de la investigación biomédica, España se encuentra ante una oportunidad única...
Continuar leyendo
|
|

|
La correcta implantación de las pruebas de cribado permitiría disminuir un tercio de las muertes anuales por cáncer colorrectal
Con más de 44.000 nuevos casos, los cánceres de colon y recto serán los más frecuentemente diagnosticados en...
Continuar leyendo
|
|

|

|
Becolve Digital lidera la transformación digital como Global Partner en Advanced Factories 2024
Becolve Digital | AVEVA Select Iberia regresa como Global Partner en la séptima edición del Advanced Factories, el encuentro...
Continuar leyendo
|
|

|
Determinan que las mutaciones del ADN mitocondrial podrían predecir el párkinson
Investigadores del CSIC, el Hospital Clínic-IDIBAPS y la Universidad de Barcelona han analizado muestras de 71 pacientes con trastornos...
Continuar leyendo
|
|

|

|
Diseñan factorías bacterianas para producir bioplásticos a partir de plásticos convencionales
Investigadores del Consejo Superior de Investigaciones Científicas (CSIC) han logrado diseñar, mediante métodos computacionales...
Continuar leyendo
|
|

|
MTBVAC, la vacuna española contra la tuberculosis inicia estudios clínicos en adultos en India
MTBVAC, la vacuna española de la tuberculosis, primera vacuna viva atenuada de Mycobacterium tuberculosis aislado de un humano, supera...
Continuar leyendo
|
|

|

|
Medicina Personalizada de Precisión, un aliado imprescindible para el desarrollo de un sistema sanitario eficiente y sostenible
La sostenibilidad y eficiencia de los sistemas sanitarios son fundamentales para poder ofrecer un acceso equitativo a la atención...
Continuar leyendo
|
|

|
Una tesis desarrolla nuevos inhibidores de proteínas involucradas en el cáncer de páncreas
El Grupo de Química Farmacéutica (GQF) de IQS School of Engineering trabaja en una línea de investigación para...
Continuar leyendo
|
|

|

|
Laboratorios acreditados por ENAC, una garantía de rigor y fiabilidad para el control del ciclo integral del agua
En el Día Mundial del Agua, que se celebra este viernes 22 de marzo, Naciones Unidas quiere poner en valor este recurso y la necesidad...
Continuar leyendo
|
|

|
Uruguay se consolida como líder regional en biotecnología
Con un enfoque estratégico en la diversificación económica y la innovación, Uruguay ha emergido como un líder...
Continuar leyendo
|
|
Artículos
|

|
Comparación entre las normativas NSI/NSF49:2019 y EN12469:2000
Una Cabina de Bioseguridad (CSB) se define como una barrera primaria parcial que depende tanto de las velocidades de aire “downflow” (o flujo vertical...
Artículo completo
|
|

|
Puentes de conocimiento
En mi experiencia diaria, ya sea buscando nuevos talentos para sumar a nuestro equipo o en mi rol de Vicedecano del Colegio de Químicos e Ingenieros...
Artículo completo
|
|

|
Uniendo Fuerzas en Oncología: La Revolución de la Perspectiva One Health
La lucha contra el cáncer se encuentra inmersa en una era de innovación sin precedentes, impulsada también en parte por la integración...
Artículo completo
|
|
Eventos recomendados
|

|
Galicia Biodays 2024
12/06/2024
Auditorio Mar, Vigo (España)
Más información
|
|

|
Farmaforum 2024
25/09/2024
IFEMA, Pabellón 9, Madrid (España)
Más información
|
|
Empresas premium
|


|
|
Este mensaje y sus adjuntos contienen información confidencial y reservada dirigida exclusivamente a su destinatario. Si ha recibido este mensaje por error, se ruega lo notifique inmediatamente por esta misma vía y borre el mensaje de su sistema. Nótese que el correo electrónico vía Internet no permite asegurar ni la confidencialidad de los mensajes que se transmiten ni la correcta recepción de los mismos. Los datos derivados de su correspondencia se incluyen en un fichero de titularidad de OMNIMEDIA, S.L. cuya finalidad exclusiva es gestionar las comunicaciones de la empresa entendiéndose que usted consiente el tratamiento de los mismos con dicha finalidad al mantener tal correspondencia. El ejercicio de sus derechos de acceso, rectificación, cancelación u oposición puede realizarlo dirigiéndose por escrito a la dirección C/ Pollensa, 2, Edif. Artemisa of. 12 de LA ROZAS (28290 - MADRID) adjuntando una fotocopia de su NIF o documento identificativo.
Este mensaje se ha enviado a {{ campaign.sender.email }} que está registrado dentro del listado de suscriptores de nuestra revista. Si no desea recibir más información y darse de baja de nuestros boletines click aquí
|